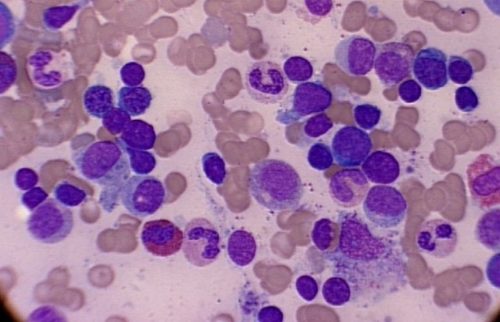

Что такое лимфоциты в крови у женщин?

Делятся они на три группы, каждая выполняет свою роль в организме:
- Т клетки – составляют от 65 до 80% всех лимфоцитов, они определяют посторонние клетки.
- В лимфоциты (от 8 до 20%) они занимаются истреблением чужеродных клеток.
- НК клетки(5-20%) – находятся на страже, защищают организм от образования раковых клеток, их еще называют натуральными киллерами.
Врачи отмечают, что нормальный уровень лимфоцитов в крови у женщин может варьироваться в зависимости от возраста. В детском возрасте, особенно в первые годы жизни, этот показатель может достигать 60-70% от общего числа лейкоцитов. С возрастом уровень лимфоцитов постепенно снижается. У женщин в подростковом возрасте нормой считается 30-45%, а в зрелом возрасте — 20-40%. В период менопаузы уровень лимфоцитов может колебаться, но обычно остается в пределах 20-35%. Важно помнить, что индивидуальные особенности организма, наличие заболеваний и стрессовые факторы могут влиять на показатели, поэтому регулярные анализы и консультации с врачом необходимы для поддержания здоровья.

Врачи отмечают, что уровень лимфоцитов в крови у женщин может варьироваться в зависимости от возраста и состояния здоровья. В норме, для женщин в возрасте от 18 до 30 лет, содержание лимфоцитов составляет от 20% до 40% от общего числа лейкоцитов. С возрастом этот показатель может немного изменяться. У женщин старше 30 лет нормальные значения остаются в пределах 19% – 37%. В период менопаузы и после 50 лет уровень лимфоцитов может снижаться, что связано с изменениями в иммунной системе. Важно учитывать, что индивидуальные особенности организма, наличие хронических заболеваний и стрессовые ситуации могут влиять на показатели. Поэтому регулярные обследования и консультации с врачом помогут поддерживать здоровье и своевременно выявлять возможные отклонения.

Функции

Узнать содержание лимфоцитов, можно сдав клинический или развернутый анализ крови. Изменение значений в любую сторону говорит о необходимости проведения дополнительных обследований. При помощи лейкоцитарной формулы, специалист ставит диагноз и назначает соответствующее лечение.
Функции лимфоцитов
- выявляют и уничтожают пораженные и чужеродные клетки;
- производят антитела;
- передают информацию следующему поколению о вирулентных клетках;
- уничтожают клетки, которые подверглись мутации;
- формируют барьер, который будет противостоять проникновению бактерий в организм;
Интересно!Самый высокий процент лимфоцитов в крови у грудничков – от 45 до 70%.
Норма лимфоцитов у взрослого человека в крови
Общепринятая норма лимфоцитарных клеток для взрослого человека любого пола от 18 до 40 %, при пересчете на абсолютное значение от 1 до 4,5 на 109/л. Однако, незначительные отклонения редко являются патологией. Незначительное колебание уровня лейкоцитов могло быть спровоцировано:
- стрессовыми ситуациями;
- чрезмерной физической активностью;
- длительным нахождением под прямыми солнечными лучами;
- алкоголем;
- недавно перенесенными вирусными заболеваниями;
- курением;
Лимфоциты играют ключевую роль в иммунной системе, и их уровень в крови может варьироваться в зависимости от возраста и состояния здоровья. У женщин нормальные показатели лимфоцитов обычно составляют от 20% до 40% от общего числа белых кровяных клеток. В молодом возрасте, особенно в подростковом, этот процент может быть выше, что связано с активным развитием иммунной системы. С возрастом, особенно после 50 лет, уровень лимфоцитов может несколько снижаться, что является естественным процессом старения. Однако важно помнить, что индивидуальные нормы могут отличаться, и любые отклонения от нормального уровня могут свидетельствовать о наличии заболеваний или инфекций. Поэтому регулярные анализы крови и консультации с врачом помогут поддерживать здоровье и своевременно реагировать на изменения.

Лимфоциты – это важные клетки иммунной системы, и их уровень в крови может варьироваться в зависимости от возраста и состояния здоровья. У женщин нормальные показатели лимфоцитов обычно составляют от 20% до 40% от общего числа лейкоцитов. В молодом возрасте, например, у девушек-подростков, этот процент может быть ближе к верхней границе нормы, так как иммунная система активно развивается. С возрастом, особенно после 50 лет, уровень лимфоцитов может немного снижаться, что связано с естественными изменениями в организме. Многие женщины отмечают, что при беременности уровень лимфоцитов может изменяться, что является нормальным явлением. Важно помнить, что для точной интерпретации результатов анализа необходимо учитывать индивидуальные особенности и консультироваться с врачом.
Норма лимфоцитов в крови у женщин: таблица

Приемлемые нормы для женщин разных указаны в расположенной ниже таблице.
| Возраст женщины | Процентное соотношение |
| 0-12 месяца | 45-69 |
| 12-24 месяца | 35-60 |
| От 2 до 4 лет | 33-52 |
| От 5 до 12 лет | 30-49 |
| От 12 до 16 лет | 30-47 |
| От 17 до 21 года | 34-44 |
| От 21 года | 20-37 |
Рост уровня лимфоцитов при беременности: причины
Количество лимфоцитов у будущей матери может изменяться в ту или иную сторону, поэтому паниковать не стоит. В 85% случаев показатели снижаются, это естественный процесс в этот период. Если самочувствие будущей мамочки вызывает опасения, доктор назначает повторные анализы. Важно!
Как определяется уровень лимфоцитов: подготовка к процедуре
Узнать уровень лимфоцитов можно при помощи обычного исследования крови. Его можно сделать как в государственной, так и в частной поликлинике. Раньше медработники самостоятельно считали количество клеток, смотря на состав через микроскоп, и рассчитывали процентное соотношение. Сейчас для этого существуют анализаторы, они самостоятельно определяют окрас, форму и численность клеток. Для того чтобы получить точный результат к исследованию необходимо подготовится.
Подготовка к анализам: рекомендации
- ужинать накануне процедуры нужно скромно, следует избегать жирной, жареной и высококалорийной пищи;
- сдавать кровь необходимо натощак;
- за 24 часа до процедуры не следует употреблять алкоголь;
- тем, кто курит, желательно воздержаться от пагубной привычки несколько часов;
Причины повышения числа лимфоцитов
Рост уровня лимфоцитов называется лимфоцитоз, он бывает абсолютным и относительным. Помимо факторов, которые связаны с образом жизни, увеличение количества лимфоцитов может сигнализировать о патологических процессах, происходящих в организме.
- бактериальных или вирусных болезней;
- процессов, которые сопровождаются гнойными выделениями, например, аппендицита;
- воспаление женских половых органов;
- онкологии;
- инфекционных болезней;
- нарушения работы вилочковой железы;
- астмы;
- интоксикация организма;
- аллергия;
Причины снижение числа лимфоцитов
Пониженный уровень лимфоцитов – называется лимфопенией. Она также различается на относительную и абсолютную. Относительная, встречается при пневмонии, лейкемическом миелозе. Абсолютная, может говорить об инфекционных болезнях, туберкулезе и онкологических заболеваниях.
Приобретенная лимфопения может быть следствием:
- несбалансированного питания;
- инфаркта;
- заболеваний инфекционной природы;
- пагубных привычек;
- лечения некоторыми препаратами;
Важно!Реже встречается врожденная лимфопения.
Как контролировать уровень лимфоцитов?
Чтобы поддерживать уровень лимфоцитов в крови на должном уровне, нужно стараться вести здоровый образ жизни, корректировать питание, избегать непосильных для организма физических нагрузок и стрессов. Росту уровня лимфоцитов способствует:
- белковая пища;
- продукты в которых содержится витамин С (апельсины, лимоны, малина, черная смородина);
- качественный, листовой, зеленый чай;
- питьевая очищенная вода в большом количестве;
Чтобы понизить уровень лимфоцитов в крови рекомендуется корректировать питание, а именно кушать: растительную белковую пищу, оливковое масло, продукты содержащие жиры.
Лечение
Как снижение, так и повышение уровня лимфоцитов в крови может быть лишь симптомом болезни. Поэтому для начала нужно выявить причину, по которой показатели сдвинулись в ту или иную сторону, а затем приступать к лечению.
Терапия заключается в устранении основного заболевания.
Поставить правильный диагноз и назначить грамотное лечение может лишь дипломированный врач.
Заключение
Незначительные колебания показателей лимфоцитов в основном не считаются признаком патологий. Чаще это следствие образа жизни или особенностей женского организма. При сильно высоких или низких показателях необходимо полностью обследоваться, чтобы вовремя выявить и вылечить болезнь.
Вопрос-ответ
Каковы нормальные значения лимфоцитов в крови у женщин в возрасте 20-30 лет?
Нормальный уровень лимфоцитов для женщин в возрасте 20-30 лет составляет примерно 20-40% от общего числа лейкоцитов. Это значение может варьироваться в зависимости от индивидуальных особенностей организма и состояния здоровья.
Как изменяются показатели лимфоцитов у женщин в период менопаузы?
В период менопаузы уровень лимфоцитов может немного снижаться, однако нормальные значения остаются в пределах 20-40%. Важно учитывать, что изменения в гормональном фоне могут влиять на иммунный ответ и, соответственно, на уровень лимфоцитов.
Каковы возможные причины отклонения уровня лимфоцитов от нормы у женщин?
Отклонение уровня лимфоцитов от нормы может быть вызвано различными факторами, включая инфекции, хронические заболевания, стресс, а также применение некоторых медикаментов. Важно обратиться к врачу для определения причины и назначения необходимого лечения.
Советы
СОВЕТ №1
Регулярно проходите медицинские обследования, чтобы контролировать уровень лимфоцитов и других клеток крови. Это поможет своевременно выявить возможные отклонения и принять необходимые меры.
СОВЕТ №2
Обратите внимание на свое питание. Употребление продуктов, богатых витаминами и минералами, таких как фрукты, овощи и орехи, может поддерживать нормальный уровень лимфоцитов и укреплять иммунную систему.
СОВЕТ №3
Следите за уровнем стресса в вашей жизни. Хронический стресс может негативно влиять на состав крови, включая уровень лимфоцитов. Практикуйте методы релаксации, такие как медитация или йога.
СОВЕТ №4
Если у вас есть хронические заболевания или вы принимаете медикаменты, обсудите с врачом, как это может повлиять на уровень лимфоцитов. Это поможет вам лучше понять свои показатели и адаптировать лечение при необходимости.